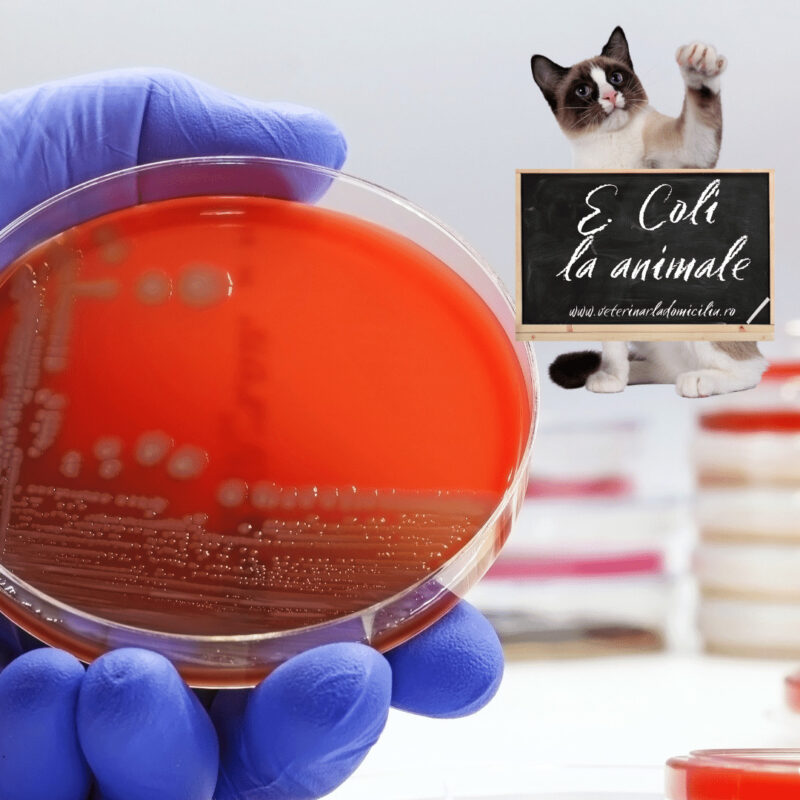
E. Coli la caini si pisici

Blog
Cum iti inveti cainele sa isi faca nevoie afara?
Dresajul cainelui pentru a-si face nevoie afara necesita in primul rand[ ... ]
„Magic mouthwash” pentru afectiuni bucale la animale
„Magic mouthwash”, tradus ar inseamna „Apa de gura magica”[ ... ]
Transplanul de fecale la caini si pisici
Transplantul de fecale (TMF), cunoscut si sub numele de transplant de[ ... ]
Itraconazol – antifungic pentru caini si pisici
Itraconazolul este un medicament antifungic, ceea ce inseamna ca lupta[ ... ]
1 comentariu
Viermele bici (whipworm) la caini
Whipworm (in engleza) sau viermele bici (in romana) este un parazit numit[ ... ]
1 comentariu
E. coli la caini si pisici
Escherichia coli, sau pe scurt E. Coli, este un tip[ ... ]
Prednison la caini si pisici
Prednisonul este un medicament ce face parte din clasa de[ ... ]
6 comentariu
Tratament – Peritonita infectioasa felina (PIF) – a doua parte
Peritonita infectioasa felina (PIF) este o boala cauzata de un virus, adesea[ ... ]
Limfomul la pisica
Limfomul la pisica este un tip de cancer al[ ... ]
Diagnostic – Peritonita infectioasa felina (PIF) – prima parte
Deoarece devine un subiect tot mai confuz pentru unii,[ ... ]